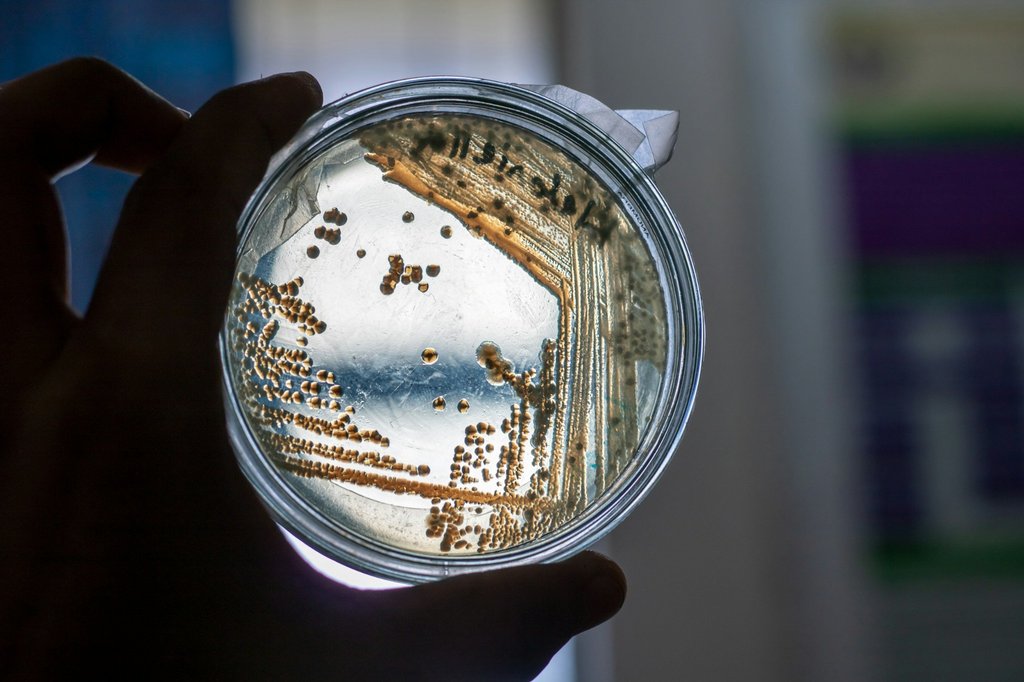
Petri dish with bacterial colonies

Rapid Phenotypic AST with SERS
Faster Answers, Better Outcomes.
Forecast Diagnostics
Forecast Diagnostics is building a new generation of rapid diagnostic tools designed to help clinicians make better treatment decisions earlier in serious infections. Our approach focuses on delivering clear, actionable insights about antibiotic effectiveness fast, so care teams can act with greater confidence when time matters most. By accelerating access to meaningful susceptibility information, Forecast aims to improve patient outcomes, support responsible antibiotic use, and modernize how bacterial infections are managed.